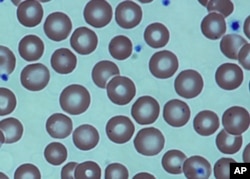
FILE - Red blood cells in a sickle cell patient, after a bone marrow transplant at the National Institutes of Health Clinical Center in Bethesda, Md. Medical Association.

Scientists at Stanford University School of Medicine have used the CRISPR gene editing tool to repair the gene that causes sickle cell disease in stem cells from diseased patients, paving the way for a potential cure for the disease, which affects up to 5 million people globally.
"What we've finally shown is that we can do it. It's not just on the chalkboard," said Dr. Matthew Porteus, senior author of the study published in the journal Nature.
With the study, and unpublished findings from his lab, Porteus believes his team has amassed enough proof to start planning the first human clinical trial using the powerful CRISPR-Cas9 gene editing system to correct the genetic mutation that causes sickle cell disease.
"We think we have a complete data set to present to the FDA (Food and Drug Administration) to say we've done all pre-clinical experiments to show this is ready for a clinical trial," Porteus told Reuters by phone.
CRISPR-Cas9 has quickly become the preferred method of gene editing in research labs because of its ease of use compared with older techniques. CRISPR works as a type of molecular scissors that can selectively trim away unwanted parts of the genome, and replace it with new stretches of DNA.
Research using the powerful technique is plowing ahead even as researchers from the University of California and the Broad Institute battle for control over the CRISPR patent. Oral arguments in the case are expected on Dec. 6 at the U.S. Patent and Trademark Office in Alexandria, Va.
In sickle cell disease, the body makes mutant, sickle-shaped hemoglobin, the protein in red blood cells that carries oxygen to the body's tissues. It is caused by a single mutation in a gene that makes a hemoglobin protein.
In a study published last month in Science Translational Medicine, a team from the University of California, Berkeley, and colleagues used the CRISPR gene editing tool to snip out the diseased gene and deliver a new stretch of DNA to correct the mutation in human stem cells.
In that study, some 25 percent of blood-forming cells were corrected.
In the Stanford study, Porteus and colleagues took a different approach. They used CRISPR to snip the gene, but they used a harmless virus to introduce the repair mechanism into cells.
After a series of tests in healthy cells, the team tested the gene editing system in blood-forming cells from four patients with sickle cell disease. They showed they could correct the mutation in 30 to 50 percent of these diseased cells.
Sixteen weeks after they injected the cells into young mice, the team found the cells were still thriving in the bone marrow.
Porteus said the findings were very encouraging because prior studies have shown that if you can correct mutations in 10 percent of cells, that should create enough to cure the disease. Stanford is now scaling up its laboratory processes to support human trials.
The process will involve using chemotherapy to wipe out a patient's blood system but not their immune system, as is done in a stem cell transplant.
Then, the team would inject the patient's own corrected stem cells, which the researchers hope would engraft into the bone marrow and produce healthy blood cells.
Porteus has equity interest in CRISPR Therapeutics of Cambridge, Massachusetts, but he said the sickle cell work has been independent of it. The university has built a cell manufacturing plant for this purpose.
"We hope to develop the entire process here at Stanford," he said.
Porteus said the team plans to make an initial submission to the FDA in the next few months to map out the clinical trial, and hopes to treat the first patient in 2018.